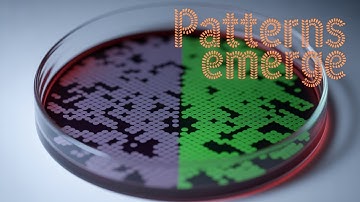
Cellulaire automaten: ondode patronen en de fysica van opkomst

⬇ DOWNLOAD NOW
Kalau muncul iklan pop-up, tutup lalu klik tombol kembali
Download lagu 2.3. Coexistence. A Three-Species Competition Model. Cellular Automata secara gratis hanya untuk keperluan promosi. Dukung artis favorit kamu dengan membeli musik original di iTunes atau platform resmi lainnya.
 Three species competitive Cellular Automata
Three species competitive Cellular Automata
 2.1. Coexistence. A Two-Species Competition Model. Cellular Automata
2.1. Coexistence. A Two-Species Competition Model. Cellular Automata
 2.2. Competitive exclusion. A Two-Species Competition Model. Cellular Automata
2.2. Competitive exclusion. A Two-Species Competition Model. Cellular Automata
 Competition Explained by Lotka-Volterra Model
Competition Explained by Lotka-Volterra Model
 The beauty of cellular automata | Sean Carroll and Lex Fridman
The beauty of cellular automata | Sean Carroll and Lex Fridman
Cellulaire automaten: ondode patronen en de fysica van opkomst
Cellulaire automaten: ondode patronen en de fysica van opkomst
 What are neural cellular automata?
What are neural cellular automata?
 6.1. Simple mechanisms of Coexistence and Competitive exclusion. Population waves
6.1. Simple mechanisms of Coexistence and Competitive exclusion. Population waves